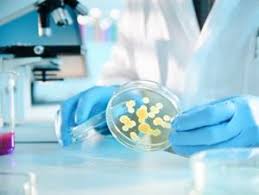
Batteri mortali le infezioni che minacciano il mondo
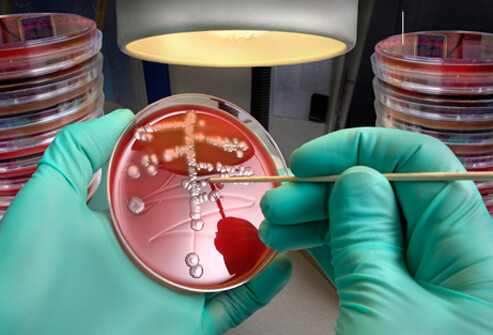

Pubblichiamo una sintesi dell’articolo denuncia del New York Times sui batteri resistenti agli antibiotici e sulla diffusione della Candida auris
By Matt Richtel and Andrew Jacobs
I batteri si stanno ribellando. Stanno ribaltando la tendenza contro gli antibiotici superando in astuzia i nostri stupefacenti farmaci.
Lo scorso anno, un uomo anziano è stato ammesso alla filiale di Brooklyn dell’Ospedale Mount Sinai per la chirurgia addominale. Un esame del sangue ha rivelato che era stato infettato da un germe appena scoperto tanto letale quanto misterioso. I medici lo hanno rapidamente isolato nell’unità di terapia intensiva.
Il germe, un fungo chiamato Candida auris, predatrice di persone con un sistema immunitario indebolito, e si sta diffondendo tranquillamente in tutto il mondo.
Negli ultimi cinque anni, ha colpito un’unità neonatale in Venezuela, ha attraversato un ospedale in Spagna, costretto un prestigioso centro medico britannico a chiudere la sua unità di terapia intensiva e messo radici in India, Pakistan e Sud Africa.

Recentemente C. auris ha raggiunto New York, New Jersey e Illinois, guidando i Centri federali per il controllo e la prevenzione delle malattie per aggiungerlo a un elenco di germi ritenuti “minacce urgenti”.
L’uomo del Monte Sinai morì dopo 90 giorni in ospedale, ma C. auris no. I test hanno dimostrato che era dappertutto nella sua stanza, così invasivo che l’ospedale aveva bisogno di attrezzature speciali per la pulizia e che doveva sradicare alcune delle mattonelle del soffitto e del pavimento per sradicarlo.
“Tutto era positivo: le pareti, il letto, le porte, le tende, i telefoni, il lavandino, la lavagna, i pali, la pompa”, ha detto il dottor Scott Lorin, presidente dell’ospedale. “Il materasso, le rotaie del letto, i fori della tanica, le tonalità della finestra, il soffitto, tutto nella stanza era positivo.”
C. auris è così tenace, in parte, perché é impermeabile ai principali farmaci antifungini, rendendolo un nuovo esempio di una delle minacce per la salute più intrattabili al mondo: l’aumento delle infezioni resistenti ai farmaci.
Il dott. Shawn Lockhart, esperto di malattie fungine presso i Centri per il controllo e la prevenzione delle malattie, tiene in mano un vetrino da microscopio con Candida auris inattiva, prelevato da un paziente americano.
Per decenni, gli esperti di salute pubblica hanno avvertito che l’uso eccessivo di antibiotici stava riducendo l’efficacia dei farmaci che hanno allungato la durata della vita curando infezioni batteriche una volta comunemente fatali. Ma ultimamente c’è stata un’esplosione di funghi resistenti, aggiungendo una nuova e spaventosa dimensione a un fenomeno che sta minando un pilastro della medicina moderna.
“È un problema enorme”, ha detto Matthew Fisher, professore di epidemiologia dei funghi all’Imperial College di Londra, coautore di una recente rassegna scientifica sull’aumento dei funghi resistenti. “Dipendiamo dal poter trattare quei pazienti con antimicotici”.
In poche parole, i funghi, proprio come i batteri, stanno evolvendo le difese per sopravvivere alle medicine moderne.
Eppure, anche se i leader della sanità mondiale hanno chiesto più cautela nella prescrizione di farmaci antimicrobici per combattere batteri e funghi – convocando l’Assemblea generale delle Nazioni Unite nel 2016 per gestire una crisi emergente – è continuato il goloso uso eccessivo di questi negli ospedali, nelle cliniche e nell’agricoltura.
I germi resistenti sono spesso chiamati “superbatteri“, ma questo è semplicistico perché in genere non uccidono tutti. Invece, sono più letali per le persone con sistemi immunitari immaturi o compromessi, compresi i neonati e gli anziani, i fumatori, i diabetici e le persone con disturbi autoimmuni che assumono steroidi che sopprimono le difese del corpo.
Gli scienziati affermano che a meno che non vengano sviluppati nuovi farmaci più efficaci e l’uso non necessario di farmaci antimicrobici sia drasticamente ridotto, il rischio si diffonderà a popolazioni più sane. Uno studio del governo britannico ha finanziato progetti che, se non fossero state messe in atto politiche per rallentare l’aumento della resistenza ai farmaci, nel 2050 circa 10 milioni di persone potrebbero morire in tutto il mondo, eclissando gli otto milioni che si prevede di morire in quell’anno per cancro.
Negli Stati Uniti, due milioni di persone contraggono annualmente infezioni resistenti e 23.000 muoiono da loro, secondo la stima ufficiale del CDC. Quel numero era basato su cifre del 2010; stime più recenti da parte dei ricercatori della Scuola di Medicina dell’Università di Washington hanno messo il bilancio delle vittime a 162.000. Le morti in tutto il mondo da infezioni resistenti si aggirerebbero sulle 700.000.
Gli antibiotici e gli antifungali sono entrambi essenziali per combattere le infezioni nelle persone, ma gli antibiotici sono anche ampiamente usati per prevenire le malattie negli animali da fattoria e gli antifungini vengono anche applicati per impedire alle piante agricole di marcire. Alcuni scienziati citano la prova che l’uso sfrenato di fungicidi sulle colture sta contribuendo all’impennata dei funghi resistenti ai farmaci che infettano gli esseri umani.